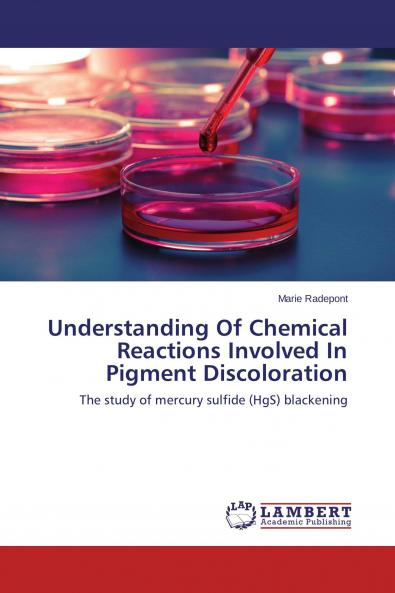
Understanding Of Chemical Reactions Involved In Pigment Discoloration

English
Paperback
₹5460
(All inclusive*)
Delivery Options
Please enter pincode to check delivery time.
*COD & Shipping Charges may apply on certain items.
Review final details at checkout.
Looking to place a bulk order? SUBMIT DETAILS
About The Book
Description
Author
Pigments form a family of compounds of which the visual stability represents the most important characteristic. Their color can sometimes evolve unexpectedly from the painter''s or curator''s point of view. This evolution is an important part of investigations in the cultural heritage field. On the other side red mercury sulfide is a pigment that is well known for its instability. For a long time its complex alteration was studied but its degradation process was far from being completely understood. The aim of this book is to assess the effects of several environmental parameters (light humidity exogenous chemicals such as chlorine...) using original artworks (six panels and two wall paintings from French and Belgium collections mainly) in order to identify factors influencing the degradation and to propose better methods of conservation.
Delivery Options
Please enter pincode to check delivery time.
*COD & Shipping Charges may apply on certain items.
Review final details at checkout.
Details
ISBN 13
9783659664793
Publication Date
-05-01-2015
Pages
-252
Weight
-346 grams
Dimensions
-150x220x13.55 mm